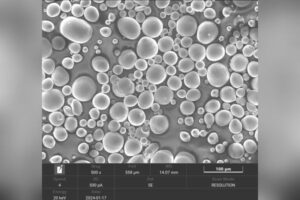
FLIR X8583 thermal imaging for NiTi alloys 3

The FLIR X8583 camera offered the high-speed, 1280 × 1024 thermal imaging the team needed to visualize inhomogeneous surface temperature distributions during mechanical loading cycles offering insights that traditional sensors could not provide.
How FLIR Empowers Advanced NiTi Alloy Research at the Hong Kong Polytechnic University.
The Challenge: Capturing Non-Uniform Thermal Behavior in Complex Materials
NiTi SMAs are among the most promising materials for solid-state refrigeration technologies, thanks to their remarkable elastocaloric effect (eCE) and superelasticity. However, accurately characterizing their thermal behavior especially under mechanical stress remains a complex challenge.
“It is well-established that the temperature of some special shape memory alloys varies under applied stress,” explains Dr. Ruien Hu, Scientific Officer at PolyU. “We previously used thermocouples to measure temperature changes, but their single-point measurement capability was insufficient to capture the non- uniform temperature distribution across specimens particularly given the heterogeneous nature of NiTi alloys.”
The Need for Full-Field, High-Speed Thermal Imaging
To overcome these limitations, Dr. Hu and his team turned to FLIR for an appropriate science-level infrared camera. They chose the FLIR X8583, a midwave, high-speed camera equipped with advanced lenses, filters, and software.
“Our experimental setup involves using a tensile testing machine to conduct tensile and compression tests on shape memory alloys,” says Dr. Hu.
“Simultaneously, the FLIR camera records and analyzes the temperature variations under stress. This capability is essential for understanding the elastocaloric response.”
The FLIR X8583 camera offered the high-speed, 1280 × 1024 thermal imaging the team needed to visualize inhomogeneous surface temperature distributions during mechanical loading cycles offering insights that traditional sensors could not provide.
Scientific Discovery: Microstructure-Driven Thermal Inhomogeneity
In a recent study, the team used Laser Powder Bed Fusion (LPBF) to fabricate NiTi alloys with near- equiatomic composition. They discovered significant inhomogeneity in the elastocaloric effect, with up to 4.2 K temperature difference across a single sample.
“Infrared imaging revealed that the surface temperature distribution was inhomogeneous during compression-induced elastocaloric effects,” Dr. Hu notes. “This was mainly due to the non-uniform microstructure of the NiTi alloys fabricated by LPBF.”
FLIR’s thermal imaging captured striped high- and low-temperature regions, helping the team link grain size, dislocation density, and precipitate distribution to the functional performance of the material.
Testimonial: The FLIR Advantage in Research
“The high resolution of the FLIR infrared camera is particularly advantageous for our research, as our specimens are relatively small. Additionally, the camera’s exceptional frame rate allows us to capture rapid temperature changes with precision critical for our analysis. FLIR has significantly enhanced our experimental capabilities, enabling us to uncover the intrinsic thermal behavior of our specimens with greater detail and accuracy,” says Dr. Hu.
Outcome: Enhanced Understanding and Scientific Impact
With FLIR’s powerful tools, the research team was able to:
- Identify the role of microstructural inhomogeneity in temperature distribution
- Capture full-field thermal responses during cyclic mechanical testing
- Gain new insights into super elasticity and functional fatigue
- Demonstrate 1% recovery after the first cycle evidence of excellent super elasticity
These findings are contributing to a broader research initiative to advance solid-state cooling technologies and adaptive material design.
Support and Future Exploration
The team also credits FLIR’s technical support for their success:
“We’ve greatly benefited from the guidance of FLIR representative Mr. Liu Yongbo, who helped resolve several technical challenges. We look forward to continued collaboration and support as our research evolves.”
Dr. Hu and his team are also interested in participating in FLIR user conferences and scientific forums to share insights and foster collaboration within the research community.
FLIR Tools in Use
- FLIR X8583 Camera
- MWIR f/4 3-5 µm MTR Lens
- Research Studio Professional Edition
- Thermographic Calibration Range: -20°C to 1500°C
Conclusion: Detect the Undetectable with the FLIR X8583
By enabling fast, full-field thermal visualization, the FLIR X8583 High-Speed Infrared Camera has become an essential research tool at PolyU.
It empowers scientists to explore the hidden thermal dynamics of advanced materials like NiTi alloys data that would be impossible to capture with conventional sensors.
The FLIR X8583 doesn’t just record temperature, it uncovers the science behind it. From revealing microstructural behaviors to accelerating innovation in smart materials and solid-state cooling, FLIR continues to push the boundaries of what’s possible in thermal research.
Discover More About FLIR X8583






